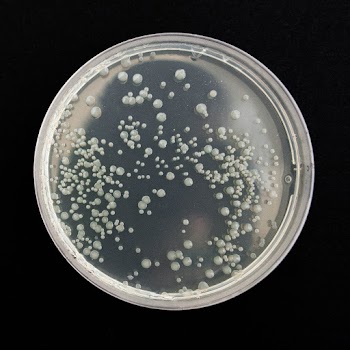

- MaterialStainless steel
- ShapeRight
- Fixing methodSurface mount
- Sink materialStainless steel
- Length0.1 cm
- ColourGrey
- ManoMano ReferenceME19395029
- Warranty25 years
- Product codeRGMRSNK033
What’s Included:
|
Made From Igneous GraniteIgneous granite is a superior material to make a kitchen sink from. It’s hygienic thanks to it’s non-porous surface, UV stable, and of course extremely durable. As the name suggests they’re made from a manufactured granite, boasting all the strength without the rough texture or appearance |
1 Bowl Sink1 bowl kitchen sinks are great as they give you one large bowl to be able to comfortably wash your pots and pans. This choice of sink is highly convenient for family kitchens and will look great in any kitchen, no matter the style. |
Inset InstallationInset sinks are to be installed on the surface of the worktop, making them extremely easy to install. They re supported by their frame and their versatility means that they re compatible with any worktop material. |
Reversible Drainer With 2 Pre-Punched Tap HolesThis sink has a drainer which can be installed either on the left or the right-hand side of the bowl. There are 2 pre-punched tap holes, one at the top and another at the bottom so you can choose which you want to knock through and fit your tap accordingly. |
Antibacterial SurfaceWhen it comes to your kitchen, you want to make sure you are keeping things clean and germ-free for the whole family. The material used the make these sinks features silver ions which is a well-documented antimicrobial. It’s been shown to kill bacteria, fungi and certain viruses making them very hygienic, an incredibly important feature in a kitchen. |
Heat Resistant To 200 DegreesFret no more about your sink as this sink is heat resistance to 200 degrees. This allows you to leave a hot pan on it without damaging or melting it’s surface. Some cheaper sinks don’t cope well with heat but this won’t be a worry anymore. |
Scratch Resistant SurfaceThe hardwearing nature of these sinks means that they re naturally great for scratch resistant and accidental damage. Drop a sharp kitchen knife or a pan? Maybe you accidentally break a glass? Whatever happens these kitchen sinks are strong enough to put up with it. |
Zero Rusting One of the best things about granite is that it’s not physically possible for it to rust. Stainless steel will only last for so long and eventually it’ll start to deteriorate but the manufacturing process for granite guarantees longevity. |
High Stain ResistanceKeep your sink look as good as new thanks to its fantastic stain resistance. Simply wipe away any marks or residue to leave your sink looking like the day you fitted it. |
UV ProtectionThanks to their UV Protection, Rangemaster kitchen sinks won t discolour or fade, even after years of use, your sink will still remain the same colour as the day you installed it. |
Ash Black FinishThe perfect sink finish for a contemporary kitchen is an ash black one from Rangemaster. They look great in any setting, bringing a real touch of quality to your home. |
Waste IncludedWith your new kitchen sink you’ll also receive a chrome basket strainer waste kit and and overflow to match. |
600mm Cabinet WidthThe style and size of your new kitchen sink is important but what a lot of people forget to check is the size of the cabinet that it s being installed into, especially if you ve had new worktops too. This sink has been designed to fit into a 600mm wide cabinet. |
You May Also Like:
|
25 Year GuaranteeWe’re so confident in the high-quality of these products that we’re more than happy to include a fantastic 25 year guarantee with them. What more could you want?! |
Dimensions: |
|

Reviews
There are no reviews yet.